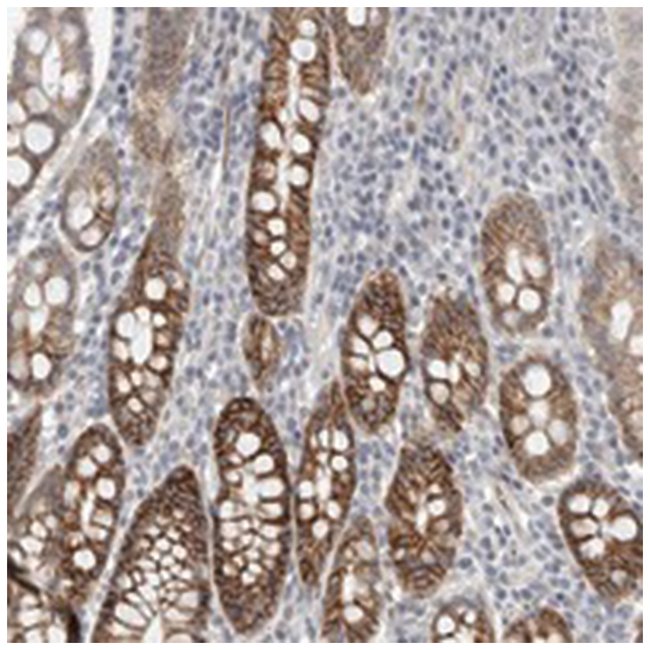

Hcn3, Rabbit, Polyclonal Antibody, Abnova, Rabbit Polyclonal Antibody Raised Against Recombinant Hcn3, Each
$ 1,757.70
|
|
Details:
Sequence: LPLSPDSPATLLARSAWRSAGSPASPLVPVRAGPWASTSRLPAPPARTLHASLSRAGRSQVSLLGPPPGGGGRRLGPRGRPLSASQPSLPQRATGDGSPGRKGSGSERLPPSGLLAKPPRTAQPPRPPVPEPATPRGLQLS
Additional Information
| SKU | 10287977 |
|---|---|
| UOM | Each |
| UNSPSC | 12352203 |
| Manufacturer Part Number | PAB21814 |
